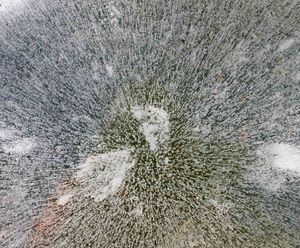

George Rebane
We may be living in a hologram, in fact the entire universe may be a hologram. The GEO600 project in Germany is geared to detect noise in the gravity wave background (think of the cosmic microwave background noise that points to the Big Bang) that would up the granularity of spacetime by about 20 orders of magnitude. This would be an important element of proof to what more scientists have proposed over the last ten to fifteen years – that our experienced three-dimensional space is really a programmed holographic projection through a two-dimensional surface somewhere. Gives rise to a lot of interesting questions – what/where is the 2-D surface? what/where are we really? what is doing the projecting? what is the running program? who is or is there a programmer? Of course, none of this can be related to a discussion of intelligent design.
We may be living in a hologram, in fact the entire universe may be a hologram. The GEO600 project in Germany is geared to detect noise in the gravity wave background (think of the cosmic microwave background noise that points to the Big Bang) that would up the granularity of spacetime by about 20 orders of magnitude. This would be an important element of proof to what more scientists have proposed over the last ten to fifteen years – that our experienced three-dimensional space is really a programmed holographic projection through a two-dimensional surface somewhere. Gives rise to a lot of interesting questions – what/where is the 2-D surface? what/where are we really? what is doing the projecting? what is the running program? who is or is there a programmer? Of course, none of this can be related to a discussion of intelligent design.
Republic, Democracy? Most true blue, flag-waving (or flag-burning) Americans don’t have a clue about the difference between those two forms of governance. During this worldwide financial crisis as we enter the new season of hopeful change, it might be good to polish up on the country our Founders bequeathed us through the Constitution. Here is short informative video that will help.
Ammunition Accountability?! As the song says, ‘If the right one don’t a get ya, then the left one will!’, and it’s a’comin’ from the left no matter that candidate Obama promised that he “won’t take our guns”, President Obama and his team will have other ideas on how to track, tax, and take your ammo. There are more ways than one to make sure our government won’t have to pry one from your cold dead hands. Here’s the status of bills making their way through state legislatures. Pro or con, you may want to contact your representatives.
Finally, for those local Readers who have yet to discover Dixie Fix, please pay a visit – Ruminations has a permanent link to her site on the right. Dixie Redfearn has made her blog into another little treasure of Nevada County. Her timely “over the back fence” commentary is informative and a joy to read. Besides, Dixie is a very nice person.


Leave a comment